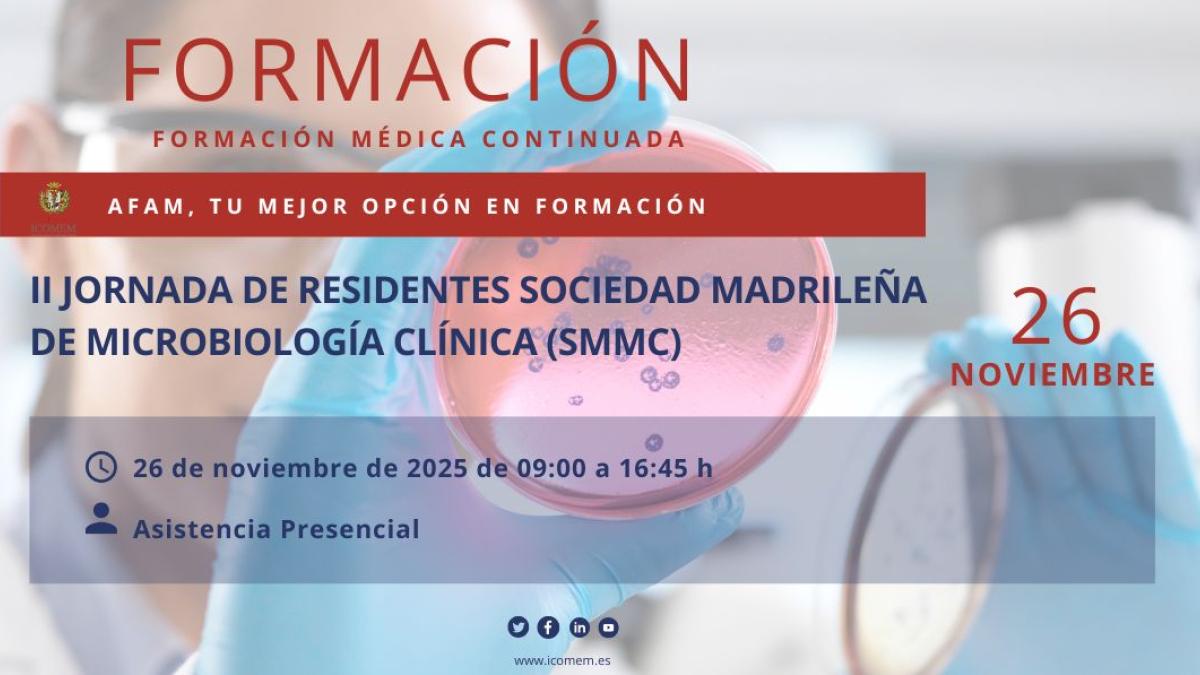

II Jornada de Residentes Sociedad Madrileña de Microbiología Clínica (SMMC)
PROGRAMA
9:00 – 9:15 | Recepción y acreditación.
9:15 – 9:30 | Apertura de la jornada
Presentación del programa y objetivos del día.
Jaime Esteban. Presidente SMMC. Paula López. Secretaria SMMC.
9:30 – 10:15 | Mesa 1: Manejo del shock séptico: diagnóstico, tratamiento y utilidad de los nuevos paneles sindrómicos
Raúl Recio (12 de Octubre) y Mª Auxiliadora Semiglia (La Princesa)
10:15 – 11:00 | Taller práctico: antibiogramas complejos: interpretación microbiológica y aplicación clínica
Patricia Ruiz Garbajosa (Ramón y Cajal). Jennifer Villa (12 de Octubre)
11:00 – 11:30 | Pausa para Café
11:30 – 12:15 | Mesa 2: Actualización en el diagnóstico de la infección fúngica invasora
Marta Martín García (Fundación Jiménez Díaz). Maricela Valerio (Hospital General Universitario Gregorio Marañón)
12:15 – 13:00 | Mesa 3: Microbiología y control de infecciones: trabajando en tándem
Adriana Rojas (Príncipe de Asturias). Sarela García-Masedo (Puerta de Hierro)
13:00 – 13:45 | Mesa 4: Serología: interpretación clínica desde Microbiología
Fátima López (Hospital La Paz). Ana Arribi y Beatriz Ensesa (Hospital Clínico)
13:45 – 14:30 | Presentación y concurso de casos clínicos preseleccionados
14:30 – 15:30 | Comida
15:30 – 16:00 | Taller práctico: Fiebre en el paciente que regresa del trópico
Juan Cuadros (Príncipe de Asturias)
16:00 – 16:45 | Simulación interactiva – ¡Tú eres el microbiólogo/a de guardia!
Sara Quevedo (Severo Ochoa). Iker Falces (La Paz)